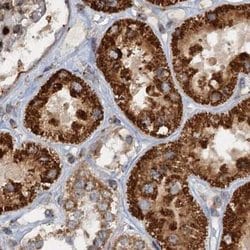
Invitrogen CEP68 Polyclonal Antibody 100 &mu;L; Unconjugated:Antibodies,

missing translation for 'onlineSavingsMsg'
Learn More
Learn More
Invitrogen™ CEP68 Polyclonal Antibody


Rabbit Polyclonal Antibody
Brand: Invitrogen™ PA559227
This item is not returnable.
View return policy
Description
Immunogen sequence: GSPQLRTRDR GWPSPRPERE KRTSQSARRP TCTESRWKSE EEVESDDEYL ALPARLTQVS SLVSYLGSIS TLVTLPT Highest antigen sequence identity to the following orthologs: Mouse - 56%, Rat - 62%.
Centrosomal protein of 68 kDa is a protein that in humans is encoded by the CEP68 gene. It is mapped to chromosome 2. CEP68 is required for centrosome cohesion. It decorates fibres emanating from the proximal ends of centrioles. CEP68 and rootletin depend both on each other for centriole association, and both also require CEP250 for their function.
Specifications
| CEP68 | |
| Polyclonal | |
| Unconjugated | |
| CEP68 | |
| 6030463E10Rik; AI481761; BC027174; centrosomal protein 68; centrosomal protein 68kDa; centrosomal protein of 68 kDa; Cep68; Kiaa0582; RGD1309101 | |
| Rabbit | |
| Antigen affinity chromatography | |
| RUO | |
| 23177 | |
| Store at 4°C short term. For long term storage, store at -20°C, avoiding freeze/thaw cycles. | |
| Liquid |
| Immunohistochemistry (Paraffin) | |
| 0.1 mg/mL | |
| PBS with 40% glycerol and 0.02% sodium azide; pH 7.2 | |
| Q76N32 | |
| CEP68 | |
| Recombinant protein corresponding to Human CEP68. Recombinant protein control fragment (Product #RP-98199). | |
| 100 μL | |
| Primary | |
| Human | |
| Antibody | |
| IgG |
Product Content Correction
Your input is important to us. Please complete this form to provide feedback related to the content on this product.
Product Title
Spot an opportunity for improvement?Share a Content Correction